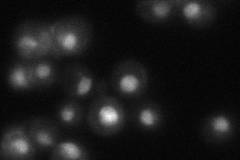
YLL036C
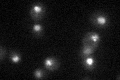
YLL036C

View description
Splicing factor associated with the spliceosome; contains a U-box, a motif found in a class of ubiquitin ligases
Localization:
Intensity:
Fold change:
Significance:
-
C’ GFP library in SD

nucleus35.96 -
N' NOP1pr-GFP in SD

cytosol,nucleus114.349 -
N' TEF2pr-mCherry in SD

ER,vacuole0 -
N' NATIVEpr-GFP in SD
nucleus37.8848 -
N' TEF2pr-VC and Cyto-VN in SD

nucleus43.4117 -
C’ GFP library in SD+DTT

nucleus40.371.12No -
C’ GFP library in SD+H2O2

nucleus34.540.96No -
C’ GFP library in Starvation Media
nucleus33.110.92No -
C’ GFP library on the background of Pup2-DaMP

nucleus -
C’ GFP library on the background of CCT mutant

nucleus32.52990.904317No
